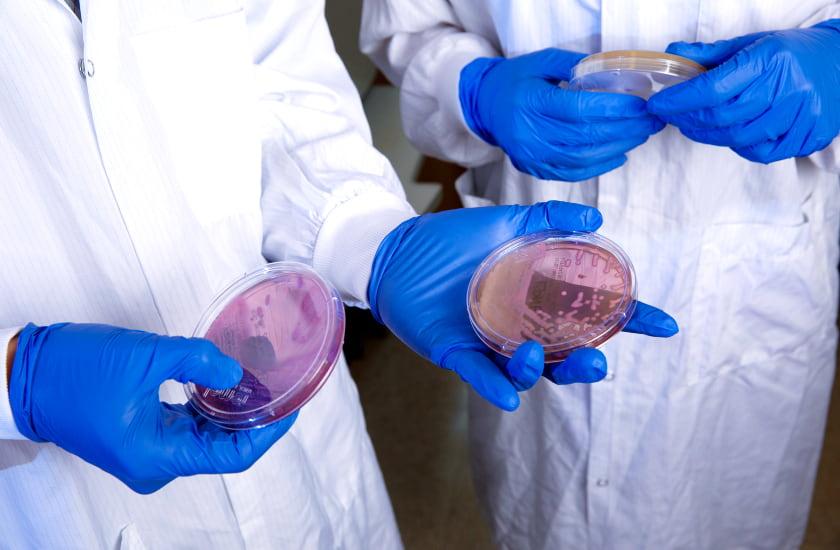

The Cohn Family Foundation provides grant funding every year to support junior faculty at Rush University who are mentees in the Rush Research Mentoring Program. The funding allows mentees to gather preliminary data for research proposals.
The following faculty were selected as 2021 Cohn Fellows after a competitive review process:

Vaskar Das, PhD, was recently promoted to assistant professor in the Department of Anesthesiology at Rush Medical College and is participating in research with Asokumar Buvanendran, MD; Jeffrey Kroin, PhD; and Robert J. McCarthy, PharmD.
He is currently working on National Institutes of Health-funded pain research as a co-investigator. His research has focused on new non-opioid treatments for acute and chronic pain by following the key energy sensor AMPK (adenosine mono-phosphate activated kinase) and the pain-relieving effect of the ketamine metabolite (2R,6R)-hydroxynorketamine.
His Cohn research will expand to assess the pain-relieving efficiency and mechanisms of AMPK activators in peripheral tissue injury pain. One immediate outcome of this research will be much-needed pharmacological understanding of AMPK activators for low back pain and post-surgical pain.

Klodian Dhana, MD, PhD, is an assistant professor in the Department of Internal Medicine at Rush Medical College. He joined Rush University in July 2018 after completing his postdoctoral training at the Harvard T.H. Chan School of Public Health.
His research focuses on epidemiology and the prevention of chronic diseases. Particularly, he investigates the role of clinical and lifestyle risk factors on cognitive health and Alzheimer's disease. The Cohn Fellowship will allow him to develop a risk prediction model for identifying stroke patients at high risk of cognitive decline and Alzheimer's dementia who can benefit from tailored preventive strategies.

Frank Ko, PhD, is an instructor in the Department of Cell and Molecular Medicine at Rush Medical College. His research interest is in the musculoskeletal system, with particular emphasis in determining the source and mechanisms of bone regeneration.
He uses the state-of-the-art imaging and genetic approaches to trace several anatomically distinct skeletal stem cells during bone healing. His Cohn research will further expand on this work, which he hopes will enhance our understanding of bone regeneration and lead to the development of novel therapies to improve orthopedic care, such as joint replacement or fracture healing.

Colleen Stiles-Shields, PhD, is an assistant professor in the Section of Community Behavioral Health and the Department of Psychiatry and Behavioral Sciences at Rush Medical College. Her research focuses on using digital mental health technology to improve mental and behavioral health for the pediatric population, particularly for those in underserved communities.
Her Cohn research will focus on determining the unmet mental and behavioral health needs of teenagers living on the West Side of Chicago and assessing their use of smartphones and mobile health tools. The results of this research will inform clinical recommendations and research efforts focusing on adolescents from underserved populations.

Lai Wang, MD, PhD, is an assistant professor in the Division of Rheumatology in the Department of Internal Medicine at Rush Medical College. Her research interest focuses on combining genetic, biochemical, cell and molecular biology approaches to explore underlying mechanisms and innovative interventions in musculoskeletal disorders and injuries.
Her current research in the Laboratory for Translational Research in Osteoarthritis focuses on molecular pathways osteoarthritis pain, as well as the role of intra-articular sensory innervation in onset and progression of osteoarthritis. Her Cohn research project will investigate whether peripheral neuronal Notch signaling contributes to joint pain in a murine surgical model of osteoarthritis.